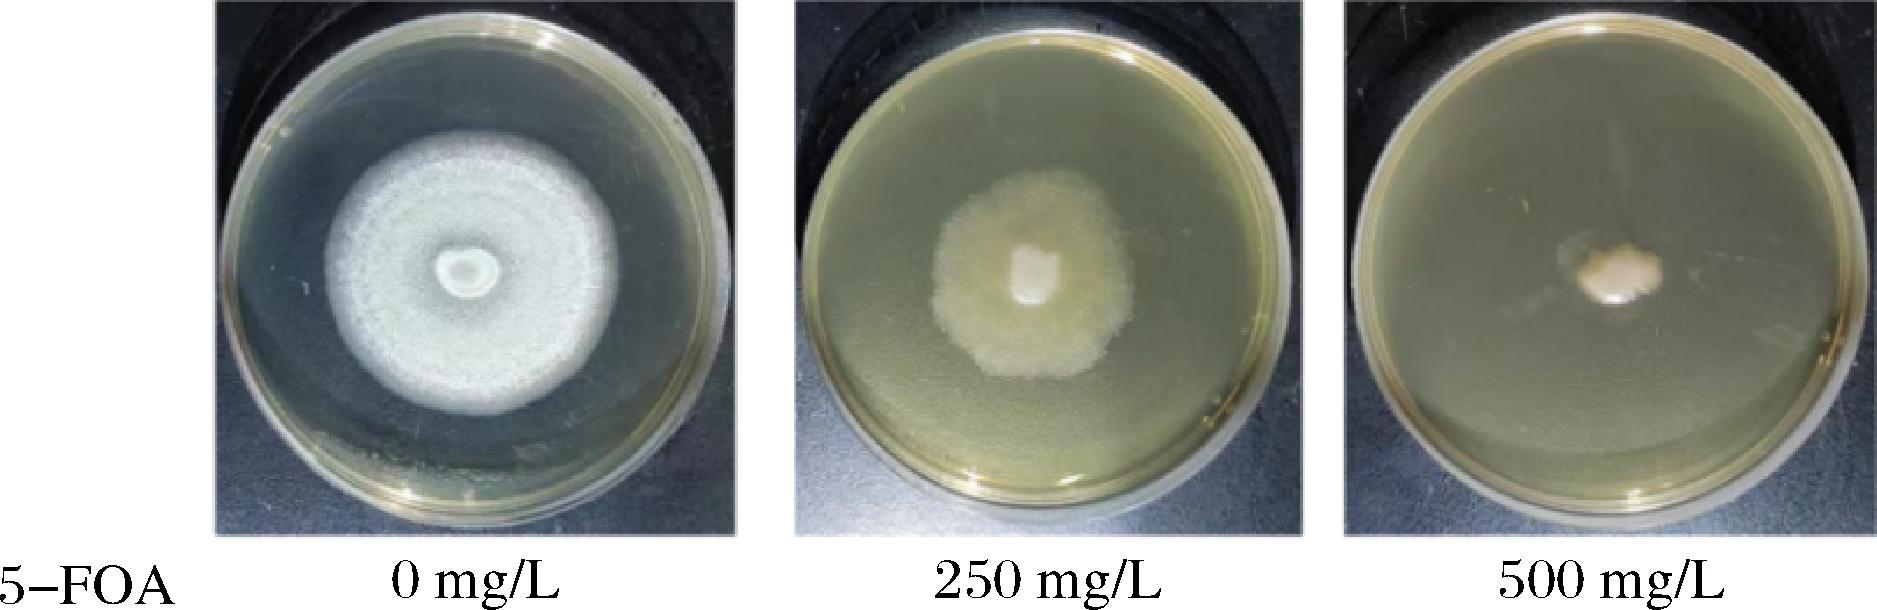
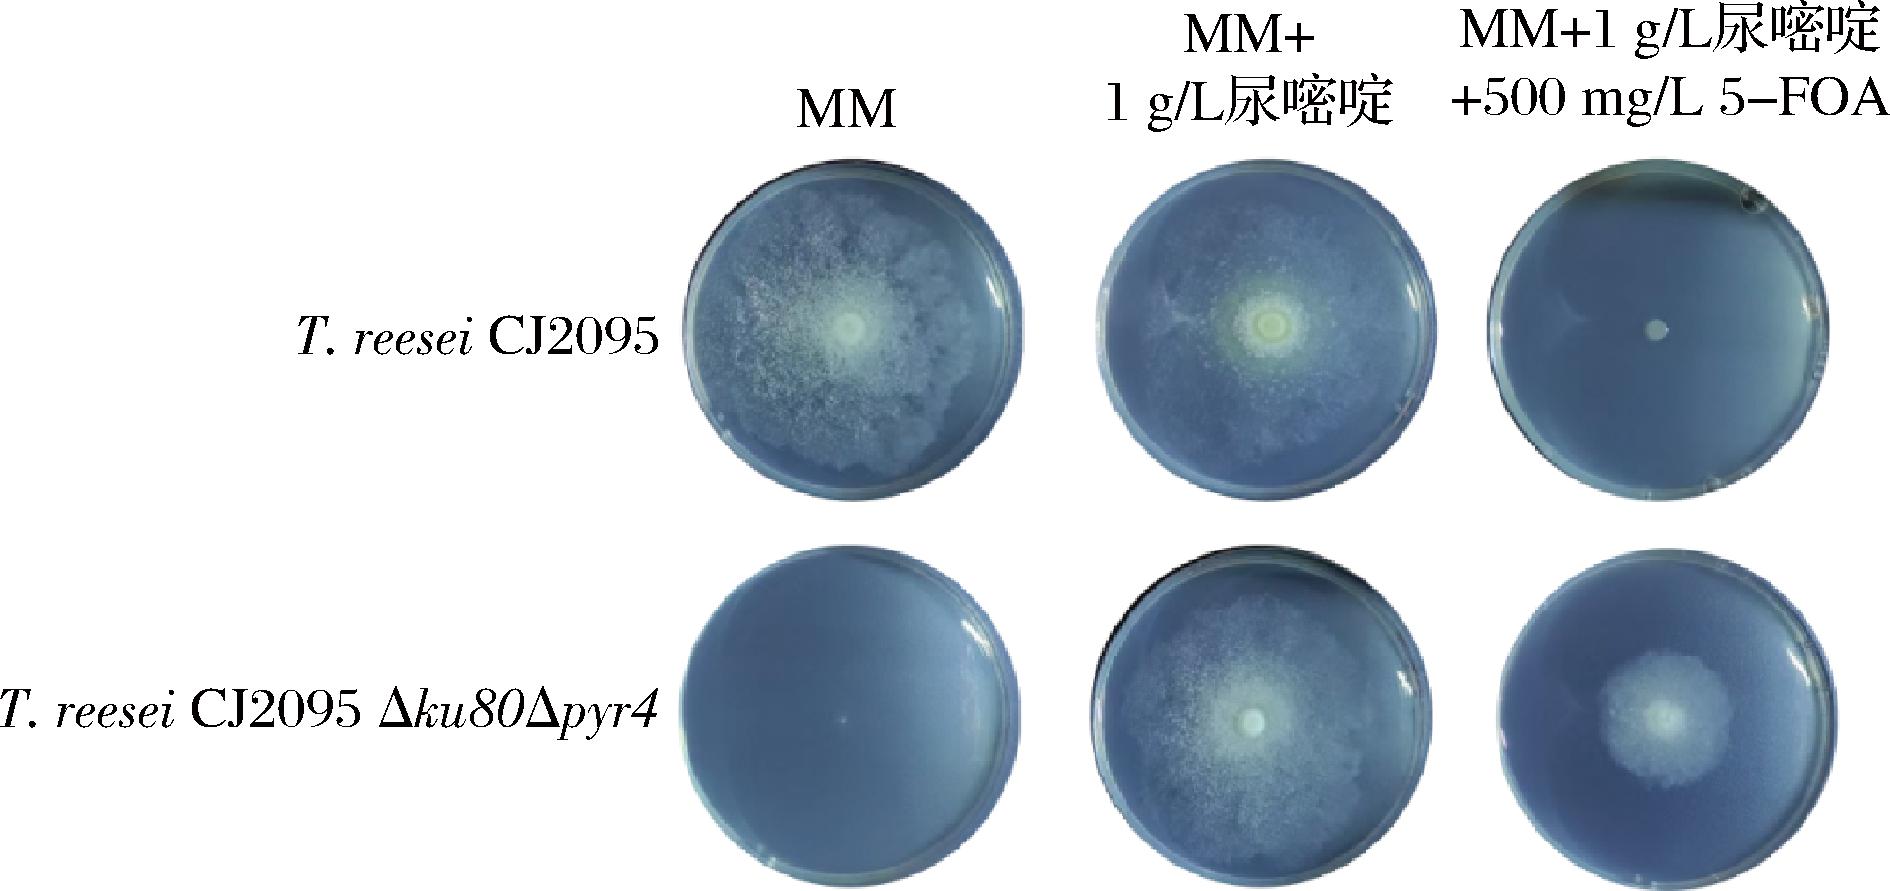

里氏木霉(Trichoderma reesei)是一种高产纤维素酶的安全丝状真菌[1]。由于其拥有强大的蛋白质表达能力,因此T.reesei成为工业生产的主力菌株。据报道,纤维素酶生产的最高滴度在工业规模上超过100 g/L[2]。LI等[3]在T.reesei中过表达了4种关键酶:八氢番茄红素合成酶/番茄红素环化酶、八氢番茄红素脱氢酶、香叶基二磷酸合酶、羟甲基戊二酰辅酶A还原酶,其纤维素酶活力达22.33 IU/mL,β-胡萝卜素的产量达286.63 mg/L,这体现了T.reesei作为生产蛋白质和萜烯类化合物等底盘细胞方面具有巨大潜力。目前,T.reesei菌株已生产了纤维素酶、木聚糖酶和植酸酶等工业酶以及衣康酸、苹果酸等有机酸,被广泛应用于食品添加剂、饲料、能源等领域[4-6]。但是,在使T.reesei成为高效的微生物蛋白质生产菌株的过程中,异源蛋白质的初始生产水平较低。例如,T.reesei中产生的几种蛋白质,包括:牛凝乳酶、黑曲霉酸性磷酸酶和黑曲霉脂肪酶,其产量均不超过1 g/L[2]。因此,通过对T.reesei进行工程化改造,获得高产菌株变得尤为重要。
然而,T.reesei的修复方式以非同源末端连接为主,同源重组发生的频率极低[7]。因此,在对T.reesei进行敲除或者定点整合时,需要挑取大量的转化子。这个过程效率低下,阻碍了T.reesei在工业化生产中的应用。CRISPR基因编辑技术已成为T.reesei基因编辑的重要手段[8]。在丝状真菌T.reesei中建立了CRISPR/Cas9系统,有效实现了同源重组,甚至使用短同源臂,在靶基因中产生位点特异性突变[9]。通过CRISPR/Cas9系统将Xyr1第873位的丙氨酸突变为酪氨酸并进行组成型表达,突变株在葡萄糖条件下的木聚糖酶与纤维素酶产量较出发菌分别提升了56.7倍和3.3倍[10]。通过CRISPR/Cas9系统从T.reesei中删除11种主要的木质纤维素降解酶和1种蛋白酶转录因子基因pea1,研究人员构建了1个可以高水平生产重组蛋白的异质性蛋白质生产平台[1]。尽管取得了显著进展,但基因编辑在T.reesei中仍面临一些挑战,如基因编辑效率如何进一步提高、基因编辑对菌株生长和代谢存在的潜在影响等。本研究中,以作者前期构建的异源表达重组人乳铁蛋白的T.reesei CJ2095为出发菌株,通过敲除DNA修复蛋白基因ku80以及过表达关键基因rad51和rad52,探究其对T.reesei CJ2095基因编辑效率的影响,并将其应用于重组人乳铁蛋白的高效生产。
1 材料与方法
1.1 材料与试剂
潮霉素B、乙酰丁香酮、利福平、头孢噻肟钠、Gel Extraction Kit和EndoFree Plasmid Mini Kit,康为世纪生物科技股份有限公司;TaKaRa Ex Taq酶,宝日医生物技术(北京)有限公司;PDA培养基,北京沃凯生物科技有限公司;人乳铁蛋白标准品,北京普西唐生物科技有限公司;人乳铁蛋白检测试剂盒,上海生工生物工程技术服务有限公司;其他所有化学品均购自中国医药集团有限公司。
1.2 菌株及质粒
大肠杆菌(Escherichia coli)JM109为基因克隆宿主。根癌农杆菌(Agrobacterium tumefaciens)AGL1为整合框转化体系。T.reesei CJ2095为改造宿主[11]。研究中使用及构建的菌株和质粒分别如表1和表2所示。
表1 研究中使用及构建的菌株
Table 1 Strains used and constructed in the study

菌株遗传特征来源E.coli JM109Cloning hostTaKaRa Bio.A. tumefaciens AGL1用于T. reesei转化 本实验室T.reesei CJ2095生产重组人乳铁蛋白的出发菌株[11]T.reesei CJ2095 Δpyr4T. reesei CJ2095 衍生菌株, 敲除pyr4 基因本研究T. reesei CJ2095 Δku80T. reesei CJ2095 衍生菌株, 敲除ku80 基因本研究T. reesei CJ2095 Δku80Δpyr4T. reesei CJ2095 衍生菌株, 敲除ku80 基因, 敲除pyr4基因本研究T. reesei CJ2095 Δku80∗T. reesei CJ2095 衍生菌株, 敲除ku80基因,包含表达框gda410-pyr4本研究T. reesei CJ2095 Δku80Δpyr4::rad51T. reesei CJ2095衍生菌株, 敲除ku80和pyr4, 包含表达框gda410-pyr4 cassette-Pgpd1-rad51-Trad51本研究T. reesei CJ2095 Δku80Δpyr4::rad52T. reesei CJ2095 衍生菌株, 敲除ku80和 pyr4, 包含表达框gda410-pyr4 cassette-Pgpd1-rad52-Trad52本研究T.reesei CJ2095 Δku80Δpyr4::rad52::xyr1T. reesei CJ2095 Δku80Δpyr4::rad52 衍生菌株, 包含表达框Pgpd1-xyr1-Txyr1本研究
表2 研究中使用及构建的质粒
Table 2 Plasmids used and constructed in the study

质粒遗传特征来源pCAMBIA1303Hygr, Kanr本实验室pCAMBIA1303-LB-RB-UPpyr4-DOWNpyr4pCAMBIA1303 衍生, 包含敲除框UPpyr4-DOWNpyr4本研究pCAMBIA1303-LB-RB-UPku80-hyg cassette-DOWNku80pCAMBIA1303 衍生, 包含敲除框UPku80-hyg cassette-DOWNku80本研究pCAMBIA1303-LB-RB-gda410-pyr4 cassette-Pgpd1-rad51-Trad51pCAMBIA1303 衍生, 包含表达框gda410-pyr4 cassette-Pgpd1-rad51-Trad51本研究pCAMBIA1303-LB-RB-gda410-pyr4 cassette-Pgpd1-rad52-Trad52pCAMBIA1303 衍生, 包含表达框gda410-pyr4 cassette-Pgpd1-rad52-Trad52本研究pCAMBIA1303-LB-RB-Pgpd1-xyr1-Txyr1-hyg cassettepCAMBIA1303 衍生,包含表达框Pgpd1-xyr1-Txyr1-hyg 本研究
1.3 仪器与设备
GI100T立式自动压力蒸汽灭菌锅,致微(厦门)仪器有限公司;MQD-B3R组合式摇床,上海旻泉仪器有限公司;DYY-6C电泳仪,北京六一生物科技有限公司;Mastercycler® nexus X2型PCR仪、Centrifuge 5430R台式高速离心机,艾本德有限公司;Tanon 3500凝胶成像仪,上海天能科技有限公司;UV-1800分光光度计,翱艺仪器(上海)有限公司;GSP-9080MBE隔水式恒温培养箱,上海博讯实业有限公司;DKT-100恒温金属浴,杭州米欧仪器有限公司;Nanodrop分光光度计,杭州奥盛仪器有限公司。
1.4 培养基
LB培养基(g/L):蛋白胨10、NaCl 10、酵母粉5。
麦芽提取物琼脂培养基(g/L):麦芽提取物30、琼脂粉20。
基本培养基(minimal medium,MM)(g/L):(NH4)2SO4 10、葡萄糖20、酵母氮源基础6.7。
发酵培养基(g/L):KH2PO4 4、(NH4)2SO4 2.8、MgSO4·7H2O 0.6、CaCl2 0.5、尿素0.6、蛋白胨3、吐温-80 1、CaCO3 5、FeSO4·7H2O 0.005、MnSO4·H2O 0.001 6、ZnSO4·7H2O 0.001 4、CoCl2·6H2O 0.002、麸皮20、微晶纤维素30。
种子培养基(g/L):葡萄糖20、K2HPO4 15、(NH4)2SO4 5、MgSO4·7H2O 0.6、CaCl2 0.6、蛋白胨2、FeSO4·7H2O 0.005、MnSO4·H2O 0.001 6、ZnSO4·7H2O 0.001 4、CoCl2·6H2O 0.002。
诱导培养基(induction medium,IM)(g/L):KH2PO4 1.45、K2HPO4 2.05、(NH4)2SO4 0.5、MgSO4·7H2O 0.5、NaCl 0.15、甘油5、CaCl2 0.06、FeSO4·7H2O 0.002 5、葡萄糖1.8、2-吗啉乙磺酸8.54、乙酰丁香酮0.039。
E.coli和A.tumefaciens在LB培养基中培养。T.reesei在PDA培养基中培养。麦芽提取物琼脂培养基用于培养T.reesei产生孢子。种子培养基和发酵培养基用于发酵培养T.reesei,生产人乳铁蛋白。IM被用于T.reesei的转化。以上培养基需要配制成固体培养基时加入15 g/L琼脂粉,培养尿嘧啶缺陷菌株时加入1 g/L的尿嘧啶。
1.5 实验方法
1.5.1 T.reesei转化
通过A.tumefaciens介导的转化法对T.reesei进行基因编辑改造[4]。将含有重组质粒的A.tumefaciens接种于含有卡那霉素和利福平的LB试管培养24~36 h。收集400 μL菌体离心,弃上清液,将菌体沉淀重悬于5 mL含有2-吗啉乙磺酸(2-morpholinoethanesulphonic acid,MES)和乙酰丁香酮的IM试管中,于30 ℃、200 r/min预培养至OD600值达到0.6~0.8,避光。取等体积的T.reesei孢子与预培养好的A.tumefaciens涂布于含有玻璃纸的IM平板上,24 ℃避光培养48 h。培养结束后,将玻璃纸转移到筛选平板,于30 ℃培养2~7 d等待转化子长出。挑取转化子至复筛平板培养1~2 d后,将菌丝挑取至含有MM培养基的2 mL离心管中培养至菌丝生长出。长出菌丝的菌株提取基因组验证,将验证正确的菌株在含有0.1%(体积分数)Triton-X100的PDA平板上划线分离单孢子,并挑选单孢子到PDA培养基进行生孢培养,最后用40%(体积分数)甘油保藏。
1.5.2 T.reesei基因组的提取
参考孟庆山[12]的方法进行操作。
1.5.3 重组质粒的构建
以敲除基因ku80的质粒pCAMBIA1303-LB-RB-UPku80-hyg casssette-DOWNku80的构建为例,其构建流程如下:以T.reesei CJ2095基因组为模板,分别以Δku80-up-FW/RS和Δku80-down-FW/RS为引物,PCR扩增获得基因ku80的上下游同源臂UPku80(1.2 kb)和DOWNku80(1.2 kb)。PCR扩增的条件为:95 ℃预变性5 min,94 ℃变性30 s;55 ℃退火30 s,72 ℃延伸(根据片段长度按照1 kb延伸1 min),循环30次;72 ℃延伸10 min。以质粒pCAMBIA1303-TrpC-Hygro-gpd1-GFP为模板,hyg (Δku80)-FW和hyg (Δku80)-RS为引物(表3),PCR扩增潮霉素抗性基因表达盒hyg cassette。以质粒pCAMBIA1303-TrpC-Hygro-gpd1-GFP为模板,以backbone-FW和backbone-RS为引物,PCR扩增出的基因片段pCAMBIA1303-LB-RB作为载体骨架。所有的PCR扩增基因片段UPku80、DOWNku80、hyg cassette、pCAMBIA1303-LB-RB,采用ClonExpress MultiS One Step Cloning Kit进行连接,连接液转化进入E.coli JM109感受态细胞,在含有终质量浓度为25 μg/mL卡那霉素的固体LB培养基上,37 ℃培养10 h。通过Δ universal validation 1-FW和Δ universal validation 4-RS为引物进行PCR扩增验证,并进行基因测序验证,筛选阳性克隆。最后,通过EndoFree Plasmid Mini Kit获得重组质粒pCAMBIA1303-LB-RB-UPku80-hyg casssette-DOWNku80。
表3 本研究中使用的引物
Table 3 Primers used in the study

引物序列(5′-3′)Δku80-up-FWTAACGCCGAATTAATTCGGGTTCTTGTTGAGGGCACGCATCTΔku80-up-RSCTCGACTTGCAATTGAGAAGATGGTTΔku80-down-FWCCAGTACTAAAATCCAGATCTATGATTATTGATGAACCGGACAAAAGGGGΔku80-down-RSACACTGATAGTTTAATTCCCTGAGAGAAGTACCGAGCGCThyg (Δku80)-FWCTTCTCAATTGCAAGTCGAGAATTCGGTCGAAAAAAGAAAAGGAGAGGhyg (Δku80)-RSGATCTGGATTTTAGTACTGGATTTTGGTTΔpyr4-up-FWTAACGCCGAATTAATTCGGGTCAAAGAGAGTGTTTGATGCTCACGΔpyr4-up-RSAAAAAAAAAAAAAAAAAAACGGCGACCACCΔpyr4-down-FWGTTTTTTTTTTTTTTTTTTTCGCCTGTACCTCTAAATGTATGCAGΔpyr4-down-RSACACTGATAGTTTAATTCCCCGCCTAGCCCGTCGTCGΔuniversal validation 1-FWCATCCGTGTTTCAAACCCGGCΔuniversal validation 4-RSCACTATAGCAGCGGAGGGGTTPgpd1(rad51)-FWGTGACATTGACATGTGATGGAAACGTTGCTAGCAGTTCCAGGPgpd1(rad51)-RSACCATGGTGATGTCTGCTCAAGCrad51-FWTGAGCAGACATCACCATGGTATGGATTACCATGCCATCCATGGCrad51-RSACACTGATAGTTTAATTCCCGCTGCAGAAGGGACATTGGGpyr4-FWTAACGCCGAATTAATTCGGGCTCACCCCCAAAGTCGCAATATCGpyr4-RSCCATCACATGTCAATGTCACAAAGGATCGgda410-FWTAACGCCGAATTAATTCGGGGTCCAAAGCCCGGCATCATAGgda410-RSCCATCACATGTCAATGTCACAAAGGATCGgda410(EcoRI)-FWCCGGAATTCCGGGGGAATTAAACTATCAGTGTTTGACAGGATATATTGgda410(XbaI)-RSCTAGTCTAGACTAGCCATCACATGTCAATGTCACAAAGGATCrad51(XbaI)-FWCTAGTCTAGACTAGCTCACCCCCAAAGTCGCAATATCG
续表3

引物序列(5′-3′)rad51(EcoRI)-RSCCGGAATTCCGGGCTGCAGAAGGGACATTGGGrad51 validation 1-FWTACTGAATTAACGCCGAATTAATTCGGGrad51 validation 1-RSTCATCCCCCCCAGAAACAGCgda410(HindIII)-RSCCCAAGCTTGGGCCATCACATGTCAATGTCACAAAGGATCrad52(HindIII)-FWCCCAAGCTTGGGCTCACCCCCAAAGTCGCAATATCGrad52(EcoRI)-RSCCGGAATTCCGGGTGGGGAGTTGTGGTGAGGGrad52-FWTGAGCAGACATCACCATGGTATGCCTGCGTATGCCCCTCrad52-RSACACTGATAGTTTAATTCCCGTGGGGAGTTGTGGTGAGGGPgpd1(xyr1)-FWTAACGCCGAATTAATTCGGGCTATGATCTTTTCACACCATGAGCGPgpd1-RSTCGATGTTGTTAGGAATGGTTATGGAxyr1-FWACCATTCCTAACAACATCGAATGTTGTCCAATCCTCTCCGTxyr1-RSACAGCCATGCTCATCGTGChyg(xyr1)-FWTGCACGATGAGCATGGCTGTAATTCGGTCGAAAAAAGAAAAGGAGAGhyg-RSACACTGATAGTTTAATTCCCGATCTGGATTTTAGTACTGGATTTTGGT
注:下划线代表相应的酶切位点。
对于pyr4基因的敲除质粒构建与上述有所不同。以T.reesei CJ2095基因组为模板,分别以Δpyr4-up-FW/RS和Δpyr4-down-FW/RS为引物,PCR扩增获得基因pyr4的上下游同源臂UPpyr4(1.2 kb)和DOWNpyr4(1.2 kb)。PCR扩增的条件为:95 ℃预变性5 min,94 ℃变性30 s;55 ℃退火30 s,72 ℃延伸(根据片段长度按照1 kb延伸1 min),循环30次;72 ℃延伸10 min。以质粒pCAMBIA1303-TrpC-Hygro-gpd1-GFP为模板,以backbone-FW和backbone-RS为引物,PCR扩增出的基因片段pCAMBIA1303-LB-RB作为载体骨架。所有的PCR扩增基因片段UPpyr4、DOWNpyr4、pCAMBIA1303-LB-RB,采用ClonExpress MultiS One Step Cloning Kit进行连接,连接液转化进入E.coli JM109感受态细胞,在含有终质量浓度为25 μg/mL卡那霉素的固体LB培养基上,37 ℃培养10 h。通过Δ universal validation 1-FW和Δ universal validation 4-RS为引物进行PCR扩增验证,并进行基因测序验证,筛选阳性克隆。最后,通过EndoFree Plasmid Mini Kit获得重组质粒pCAMBIA1303-LB-RB-UPpyr4-DOWNpyr4。
对于过表达rad51基因和rad52基因,由于pyr4筛选标记框含有同源片段gad410,所以过表达rad51基因和rad52基因的重组质粒需要使用一步克隆试剂盒和酶切连接2种方式进行构建。以质粒pCAMBIA1303-TrpC-Hygro-gpd1-GFP为模板,Pgpd1(rad51)-FW和Pgpd1(rad51)-RS为引物,PCR扩增获得基因gpd1的启动子Pgpd1。以T.reesei CJ2095基因组为模板,rad51-FW和rad51-RS为引物,PCR扩增获得基因rad51及其终止子片段Trad51。以T.reesei CJ2095基因组为模板,pyr4-FW和pyr4-RS为引物,PCR扩增获得pyr4筛选标记框(pyr4 cassette)。以T.reesei CJ2095基因组为模板,gda410-FW和gda410-RS为引物,PCR扩增获得来源于pyr4筛选标记框的同源片段gda410,用于pyr4筛选标记框的弹出。PCR扩增的条件为:95 ℃预变性5 min,94 ℃变性30 s;55 ℃退火30 s,72 ℃延伸(根据片段长度按照1 kb延伸1 min),循环30次;72 ℃延伸10 min。以质粒pCAMBIA1303-TrpC-Hygro-gpd1-GFP为模板,backbone-FW和backbone-RS为引物,PCR扩增出的基因片段pCAMBIA1303-LB-RB作为载体骨架。上述同源片段gda410与基因片段pCAMBIA1303-LB-RB通过一步克隆试剂盒ClonExpress MultiS One Step Cloning Kit进行连接。接着,提取验证正确后的阳性转化子的重组质粒,gda410(EcoRI)-FW和gda410(XbaI)-RS为引物,全质粒PCR扩增获得含有EcoRI和XbaI的载体片段pCAMBIA1303-LB-RB-gda410。另外,以上述pyr4筛选标记框、Pgpd1、基因rad51及其终止子片段Trad51和基因片段pCAMBIA1303-LB-RB通过一步克隆试剂盒ClonExpress MultiS One Step Cloning Kit进行连接。接着,提取验证正确后的阳性转化子的重组质粒,rad51(XbaI)-FW和rad51(EcoRI)-RS为引物,PCR扩增获得含有EcoRI和XbaI的基因片段pyr4 cassette-rad51-Trad51。最后,将载体片段pCAMBIA1303-LB-RB-gda410与基因片段pyr4 cassette-rad51-Trad51通过EcoR I和Xba I双酶切进行连接,将连接液转化进入E.coli JM109感受态细胞,在含有终质量浓度为25 μg/mL卡那霉素的固体LB培养基上,37 ℃培养10 h。采用rad51 validation-FW和rad51 validation-RS为引物,进行PCR扩增验证,并进行基因测序验证,筛选阳性克隆。通过EndoFree Plasmid Mini Kit获得重组质粒pCAMBIA1303-LB-RB-gda410-pyr4 cassette-Pgpd1-rad51-Trad51。过表达基因rad52的重组质粒的构建流程同上。但是由于酶切位点的限制,过表达基因rad52的重组质粒的构建使用酶切连接时,选择EcoR I和Hind III作为酶切位点进行连接。本研究使用的引物如表3所示。
1.5.4 pyr4筛选标记框的弹出
将成熟的孢子用孢子洗脱液从固体生孢培养基上洗涤下来,涂布于含有500 mg/L的5-氟乳清酸(5-fluoroorotic acid,5-FOA)和1 g/L尿嘧啶的固体MM培养基上。放置于30 ℃培养3~5 d,等待菌丝长出。挑取菌丝于复筛培养基上(含有500 mg/L的5-FOA和1 g/L尿嘧啶的固体MM培养基)。菌丝再次长出时,挑取至含有500 mg/L 5-FOA和1 g/L尿嘧啶的MM液体培养基中培养至菌丝生长出。最后,将长出菌丝的菌株提取基因组验证。
1.5.5 摇瓶发酵产人乳铁蛋白
种子培养:使用T.reesei孢子洗脱液[含有0.5 g/L吐温-80的生理盐水]将麦芽提取物琼脂培养基上的T.reesei孢子洗脱下来,接种于100 mL种子培养基(500 mL三角瓶)中,T.reesei孢子终浓度为1×106个/mL,在30 ℃、200 r/min条件下培养48 h。
摇瓶发酵培养:以10%接种量,将种子液转接于100 mL发酵培养基(500 mL三角瓶)中,在30 ℃、200 r/min条件下培养7 d。
1.5.6 纤维素酶的滤纸酶活力的测定
纤维素酶的滤纸酶活力通过3,5-二硝基水杨酸(3,5-dinitrosalicylic acid,DNS)方法测定[4]:取3块直径为6 mm的滤纸放入2 mL EP离心管中,加入180 μL 0.05 mol/L的柠檬酸钠缓冲液(pH 4.8)。加入20 μL酶液,50 ℃反应60 min。加入300 μL DNS试剂沸水浴5 min,冰浴降温。取50 μL反应结束的混合液与150 μL去离子水混合检测540 nm处的吸光值A540。纤维素酶的滤纸酶活力(U)定义为:在上述条件下,每1 min催化底物生成1 μmol葡萄糖所需要的酶量为1个酶活力单位(U)。
2 结果与讨论
2.1 DNA修复蛋白基因ku70和ku80的敲除
T.reesei的修复模式主要是以非同源末端连接为主,同源重组为辅[13]。因此,T.reesei中的同源重组效率极其低下。据报道,非同源末端连接相关基因的破坏已被发现是提高同源重组效率的有效策略之一,其中DNA修复蛋白基因ku70和ku80是被广泛研究的2种非同源末端连接相关基因;当T.reesei敲除ku70基因后,通过原生质体转化法将同源臂为1 kb的基因敲除片段转化进入T.reesei中,其同源重组率从之前的5%~10%提高到95%以上[14-16]。
本研究中选择基因ku70和ku80作为提高T.reesei基因编辑效率的关键基因。通过将含有重组质粒pCAMBIA1303-LB-RB-UPku70-hyg casssette-DOWNku70、pCAMBIA1303-LB-RB-UPku80-hyg casssette-DOWNku80的A.tumefaciens与出发菌株T.reesei CJ2095共培养,进而敲除基因ku70、ku80,获得重组菌株T.reesei CJ2095 Δku70、T.reesei CJ2095 Δku80(图1-a)。经过PCR验证和DNA测序,成功构建T.reesei CJ2095 Δku80(图1-c)。然而,经多次重复实验,未获得正确的T.reesei CJ2095 Δku70阳性转化子。因此,最终选择重组菌株T.reesei CJ2095 Δku80进行后续实验操作。

a-ku80基因敲除质粒构建示意图;b-ku80基因敲除示意图;c-ku80基因敲除核酸验证胶图
图1 敲除ku80基因的重组质粒构建及阳性克隆验证
Fig.1 Construction of recombinant plasmids and verification of positive colonies with knocking out the ku80 gene
注:blank表示对照;M表示marker,下同。
2.2 5-FOA工作质量浓度优化
为了验证DNA修复蛋白ku80基因敲除对T.reesei的基因编辑效率的影响,研究中进一步敲除了T.reesei中的乳清酸核苷-5′-磷酸脱羧酶pyr4基因。
pyr4基因自身作为筛选标记,当T.reesei中缺少pyr4基因时,会导致乳清酸核苷-5′-磷酸脱羧酶失活,敲除该基因的T.reesei工程菌株在后续生长过程中必须额外添加尿嘧啶才能正常生长。另外,如果培养基中含有5-FOA,含有基因pyr4的野生型菌株不可以生长,而缺少pyr4基因的重组T.reesei菌株则可以生长[17]。因此,在构建pyr4基因敲除框时,不需要潮霉素基因作为筛选标记,当筛选阳性转化子时,只需要在筛选培养基中加入5-FOA作为筛选压力即可。同时,作为尿嘧啶营养缺陷型菌株在培养时需要额外添加尿嘧啶。研究中对5-FOA的最佳工作浓度进行了优化。当PDA固体培养基的5-FOA工作质量浓度为250 mg/L时,T.reesei CJ2095生长已经受到抑制;当质量浓度为500 mg/L时,T.reesei CJ2095则完全无法生长(图2)。因此,选择5-FOA的工作质量浓度为500 mg/L用于进行后续实验。
图2 5-FOA工作浓度的评价
Fig.2 Evaluation of the working concentrations of 5-FOA
2.3 敲除ku80基因对T.reesei基因编辑效率的影响
研究中,在菌株T.reesei CJ2095和T.reesei CJ2095 Δku80中分别敲除基因pyr4,用于验证敲除ku80基因对T.reesei基因编辑效率的影响(图3-a)。如图3-c所示,PCR验证的结果显示,T.reesei CJ2095中基因pyr4的敲除效率很低,其阳性敲除率仅为1.04%。当敲除基因ku80后,重组菌株T.reesei CJ2095 Δku80中再次敲除基因pyr4时,其阳性敲除率由对照菌株T.reesei CJ2095的1.04%提高至7.14%(图3-b和图3-c)。

a-pyr4基因敲除质粒构建示意图;b-pyr4基因敲除核酸验证胶图(红色箭头指示pyr4被正确敲除的泳道);c-ku80基因敲除后对pyr4基因敲除效率的影响
图3 敲除ku80基因对T.reesei基因编辑效率的影响
Fig.3 Effect of knocking out the ku80 gene on gene editing efficiency of T.reesei
如图4所示,在表型验证中发现,重组菌株T.reesei CJ2095 Δku80Δpyr4在MM培养基上无法生长,但在MM+1 g/L尿嘧啶培养基以及MM+1 g/L尿嘧啶+500 mg/L 5-FOA培养基上均可以正常生长。pyr4基因敲除后的菌株T.reesei CJ2095 Δku80Δpyr4无法在MM培养基中生长,只能生长在含有1 g/L尿嘧啶的培养基中(图4)。结果表明,敲除非同源末端连接的基因ku80可以显著提高T.reesei的基因编辑效率。
图4 重组菌株T. reesei CJ2095 Δku80Δpyr4的表型验证
Fig.4 Phenotypic validation of the recombinant strain T.reesei CJ2095 Δku80Δpyr4
2.4 过表达关键酶基因rad51或rad52增强重组菌株T.reesei CJ2095 Δku80Δpyr4的基因编辑效率
本研究进一步通过过表达同源重组酶基因rad51或rad52[18],提高T.reesei的基因编辑效率。同时,为了能够实现pyr4筛选标记基因的循环使用以及对比rad51、rad52基因过表达后重组菌株的同源重组效率是否提高,构建过表达质粒时在pyr4筛选标记基因前添加大小为410 bp的同源基因片段gda410(图5-a)。当同源重组发生时,gda410与pyr4筛选标记基因发生同源重组,从而去除pyr4基因,只保留gda410基因片段,实现了pyr4筛选标记基因的循环使用(图5-d)。

a-过表达rad51基因和rad52基因质粒构建示意图;b-pyr4筛选标记弹出验证(红色箭头指示目的基因片段);c-pyr4筛选标记弹出效率;d-pyr4筛选标记弹出示意图
图5 过表达关键酶基因rad51或rad52对T.reesei基因编辑效率的影响
Fig.5 Effect of overexpressing the genes rad51 or rad52 on gene editing efficiency of T.reesei
注:blank表示对照;M表示核酸marker;primer表示引物;1、2、3、4、5表示转化子序号。
通过A.tumefaciens介导的转化法,进一步构建获得了重组菌株T.reesei CJ2095 Δku80Δpyr4::rad51和T.reesei CJ2095 Δku80Δpyr4::rad52以及恢复pyr4筛选标记基因的重组菌株T.reesei CJ2095 Δku80*。将重组菌株T.reesei CJ2095 Δku80Δpyr4::rad51、T.reesei CJ2095 Δku80Δpyr4::rad52和T.reesei CJ2095 Δku80*的孢子涂布到含有500 mg/L 5-FOA和1 g/L尿嘧啶的MM固体培养基上培养3~5 d。将长出的菌株进一步接种到复筛板上(含有500 mg/L 5-FOA和1 g/L尿嘧啶的MM固体培养基),提取其基因组进行PCR验证,通过PCR验证确定pyr4筛选标记基因正确弹出的菌株。如图5-b所示,当pyr4筛选标记基因被正确弹出时,采用引物Primer 1和Primer 3无法扩增到目标条带;而采用引物Primer 2和Primer 3可以扩增到大小为2 076 bp的基因片段。当pyr4筛选标记基因被正确弹出时,菌株T.reesei CJ2095 Δku80*则无法扩增到大小为934 bp的基因片段,而未弹出的菌株则可以扩增到相应的基因片段。
研究中,测定分析了T.reesei CJ2095 Δku80Δpyr4::rad51、T.reesei CJ2095 Δku80Δpyr4::rad52和T.reesei CJ2095 Δku80*重组菌株的pyr4筛选标记基因的弹出率。针对重组菌株T.reesei CJ2095 Δku80Δpyr4::rad51,从48个转化子中验证挑选到了6个阳性转化子,pyr4筛选标记基因弹出率为12.50%(图5-c)。同样的,重组菌株T.reesei CJ2095 Δku80Δpyr4::rad52的pyr4筛选标记基因弹出率提高至43.75%(图5-c)。T.reesei CJ2095 Δku80*筛选标记基因弹出率为8.33%(图5-c)。结果表明,重组菌株T.reesei CJ2095 Δku80Δpyr4::rad52的pyr4筛选标记基因的弹出效率明显强于重组菌株T.reesei CJ2095 Δku80Δpyr4::rad51,说明过表达rad52基因后T.reesei的同源重组能力有显著提升。
2.5 过表达木聚糖酶调节因子1基因xyr1进一步验证T.reesei CJ2095 Δku80Δpyr4::rad52的基因编辑效率
木聚糖酶调节因子1基因xyr1可以激活启动子Pcbh1的转录[19]。LYU等[20]将突变增强后的木聚糖酶调节因子1基因xyr1在T.reesei中进行过表达后发现,纤维二糖水解酶I基因cbh1、纤维二糖水解酶Ⅱ基因cbh2、β-葡萄糖苷酶基因bgl1等主要纤维素酶基因的mRNA水平显著上调0.5~3.0倍,结果表明:基因xyr1在激活启动子Pcbh1的转录方面具有正向的效果。因为,T.reesei CJ2095中的重组人乳铁蛋白基因由启动子Pcbh1调控。因此,本研究通过过表达xyr1基因来进一步验证重组菌株T.reesei CJ2095 Δku80Δpyr4::rad52的基因编辑效率,并增强重组人乳铁蛋白基因的表达水平。
在T.reesei中以随机整合的方法过表达基因xyr1时,其基因重组效率达83.33%,进一步验证了重组菌株T.reesei CJ2095 Δku80Δpyr4::rad52的高基因编辑效率。同时,与对照菌株重组菌株T.reesei CJ2095 Δku80Δpyr4::rad52相比较,重组菌T.reesei CJ2095 Δku80Δpyr4::rad52::xyr1的重组人乳铁蛋白产量提高了22.21%,产量达234.64 mg/L(图6-b和图6-d)。与对照菌株T.reesei CJ2095 Δku80Δpyr4::rad52相比较,菌株T.reesei CJ2095 Δku80Δpyr4::rad52::xyr1的发酵上清液中的纤维素酶滤纸酶活力也获得提高,其纤维素酶滤纸酶活力由对照菌T.reesei CJ2095 Δku80Δpyr4::rad52的1.34 U/mL提高至1.49 U/mL(图6-c)。本研究为首次通过代谢工程改造策略改造T.reesei,实现其重组人乳铁蛋白的高效生产。

a-过表达xyr1基因质粒构建示意图;b-重组人乳铁蛋白的生产;c-纤维素滤纸酶活力;d-过表达xyr1基因后SDS-PAGE分析;e-标准重组人乳铁蛋白SDS-PAGE分析
图6 过表达木聚糖酶调节因子1基因xyr1进一步验证T.reesei CJ2095 Δku80Δpyr4::rad52的基因编辑效率
Fig.6 Verification of gene editing efficiency of T.reesei CJ2095 Δku80Δpyr4::rad52 via over-expressing the xylanase regulator 1 gene xyr1
注:图b中,1,T.reesei CJ2095 Δku80Δpyr4::rad52;2,T.reesei CJ2095 Δku80Δpyr4::rad52::xyr1;图c中,1,T.reesei CJ2095 Δku80Δpyr4::rad52;2,T.reesei CJ2095 Δku80Δpyr4::rad52::xyr1;图d中,M,Marker(标准分子质量蛋白);泳道1,T.reesei CJ2095 Δku80Δpyr4::rad52;泳道2,T.reesei CJ2095 Δku80Δpyr4::rad52::xyr1;红色箭头指示目标蛋白。
3 结论
为了提高T. reesei CJ2095的基因编辑效率,研究中通过敲除DNA修复蛋白基因ku80显著提高了其基因编辑效率,与对照相比较,基因编辑效率提高了6.8倍。通过在T.reesei CJ2095 Δku80重组菌株中,分别过表达T.reesei内源的基因rad51或rad52,分别构建获得重组菌株T.reesei CJ2095 Δku80Δpyr4::rad51、T.reesei CJ2095 Δku80Δpyr4::rad52,其同源重组效率提高至T.reesei CJ2095 Δku80*的1.5倍和5.2倍。同时,为了实现筛选标记基因pyr4的循环使用,敲除了T.reesei CJ2095 Δku80菌株中pyr4基因作为后面菌株基因编辑的循环筛选标记基因。通过过表达基因xyr1来进一步验证重组菌株T.reesei CJ2095 Δku80Δpyr4::rad52的基因编辑效率,并增强了重组人乳铁蛋白基因的表达水平(产量达234.64 mg/L),本研究为首次通过代谢工程改造策略改造T.reesei实现其重组人乳铁蛋白的高效生产。
[1] CHAI S X, ZHU Z H, TIAN E N, et al.Building a versatile protein production platform using engineered Trichoderma reesei[J].ACS Synthetic Biology, 2022, 11(1):486-496.
[2] JI W L, WANG X L, LIU X Q, et al.Combining manipulation of integration loci and secretory pathway on expression of an Aspergillus niger glucose oxidase gene in Trichoderma reesei[J].Microbial Cell Factories, 2023, 22(1):38.
[3] LI J, CHEN Y M, GAO A, et al.Simultaneous production of cellulase and β-carotene in the filamentous fungus Trichoderma reesei[J].Journal of Agricultural and Food Chemistry, 2023, 71(16):6358-6365.
[4] 闫肃. 里氏木霉中纤维素酶的诱导调控机制与重组蛋白的表达优化[D].无锡:江南大学, 2023.
YAN S.Induction and regulation mechanism of cellulase in Trichoderma reesei and expression optimization of recombinant protein[D].Wuxi:Jiangnan University, 2023.
[5] CHEN Y M, WANG Z W, CHEN C C, et al.Metabolic engineering of filamentous fungus Trichoderma reesei for itaconic acid production[J].Journal of Agricultural and Food Chemistry, 2025, 73(8):4716-4724.
[6] CHEN Y M, WANG J J, WANG M, et al.Engineering the metabolism and morphology of the filamentous fungus Trichoderma reesei for efficient L-malic acid production[J].Bioresource Technology, 2023, 387:129629.
[7] 张磊. 里氏木霉连续基因打靶系统的设计以及DNA修复相关基因的研究[D].上海:华东理工大学, 2016.
ZHANG L.Development of a continuous gene targeting toolbox and identification of a three-gene cluster related to DNA repair in Trichoderma reesei[D].Shanghai:East China University of Science and Technology, 2016.
[8] 张佳欣. CRISPR/Cas9技术在里氏木霉纤维素酶系改良和异源蛋白表达分泌中的应用[D].济南:山东大学, 2022.
ZHANG J X.Application of CRISPR/Cas9 technology for improving cellulolytic enzymes and expressing heterologous protein in Trichoderma reesei[D].Jinan:Shandong University, 2022.
[9] LIU R, CHEN L, JIANG Y P, et al.Efficient genome editing in filamentous fungus Trichoderma reesei using the CRISPR/Cas9 system[J].Cell Discovery, 2015, 1:15007.
[10] 邢翠霞, 夏雨潇, 张伟欣, 等.里氏木霉纤维素酶基因表达与调控[J].微生物学通报, 2024, 51(12):4884-4898.
XING C X, XIA Y X, ZHANG W X, et al.Progress in the cellulase gene expression and regulation in Trichoderma reesei[J].Microbiology China, 2024, 51(12):4884-4898.
[11] 陈献忠, 胡传俊, 沈微, 等.一株稳定表达人乳铁蛋白的里氏木霉菌株及其应用:中国, CN117487675A[P].2024-02-02.
CHEN X Z, HU C J, SHEN W, et al.Trichoderma reesei strain capable of stably expressing human lactoferrin and its application:China, CN117487675A[P].2024-02-02.
[12] 孟庆山. 里氏木霉纤维素酶基因转录调控因子鉴定及纤维素酶高产菌株构建[D].大连:大连理工大学,2019.
MENG Q S.Identification of transcription factors controlling expression of cellulolytic enzymes in Trichoderma reesei and development of robust strains for improved cellulase production[D].Dalian:Dalian University of Technology, 2019.
[13] ZHANG J X, LI K H, SUN Y, et al.An efficient CRISPR/Cas9 genome editing system based on a multiple sgRNA processing platform in Trichoderma reesei for strain improvement and enzyme production[J].Biotechnology for Biofuels and Bioproducts, 2024, 17(1):22.
[14] LIEBER M R.The mechanism of human nonhomologous DNA end joining[J].Journal of Biological Chemistry, 2008, 283(1):1-5.
[15] NINOMIYA Y, SUZUKI K, ISHII C, et al.Highly efficient gene replacements in Neurospora strains deficient for nonhomologous end-joining[J].Proceedings of the National Academy of Sciences of the United States of America, 2004, 101(33):12248-12253.
[16] ZHANG G T, HARTL L, SCHUSTER A, et al.Gene targeting in a nonhomologous end joining deficient Hypocrea jecorina[J].Journal of Biotechnology, 2009, 139(2):146-151.
[17] 张利华. 热带假丝酵母遗传操作系统的建立及在二元酸合成中的应用[D].无锡:江南大学, 2016.
ZHANG L H.Development of the genetic manipulation system for Candida tropicalis and its application in dicarboxylic acid production[D].Wuxi:Jiangnan University, 2016.
[18] CAI P, DUAN X P, WU X Y, et al.Recombination machinery engineering facilitates metabolic engineering of the industrial yeast Pichia pastorisOpen Access[J].Nucleic Acids Research, 2021, 49(13):7791-7805.
[19] SUN X H, ZHANG X H, HUANG H Q, et al.Engineering the cbh1 promoter of Trichoderma reesei for enhanced protein production by replacing the binding sites of a transcription repressor ACE1 to those of the activators[J].Journal of Agricultural and Food Chemistry, 2020, 68(5):1337-1346.
[20] LYU D M, ZHANG W X, MENG X F, et al.Single mutation in transcriptional activator Xyr1 enhances cellulase and xylanase production in Trichoderma reesei on glucose[J].Journal of Agricultural and Food Chemistry, 2023, 71(31):11993-12003.